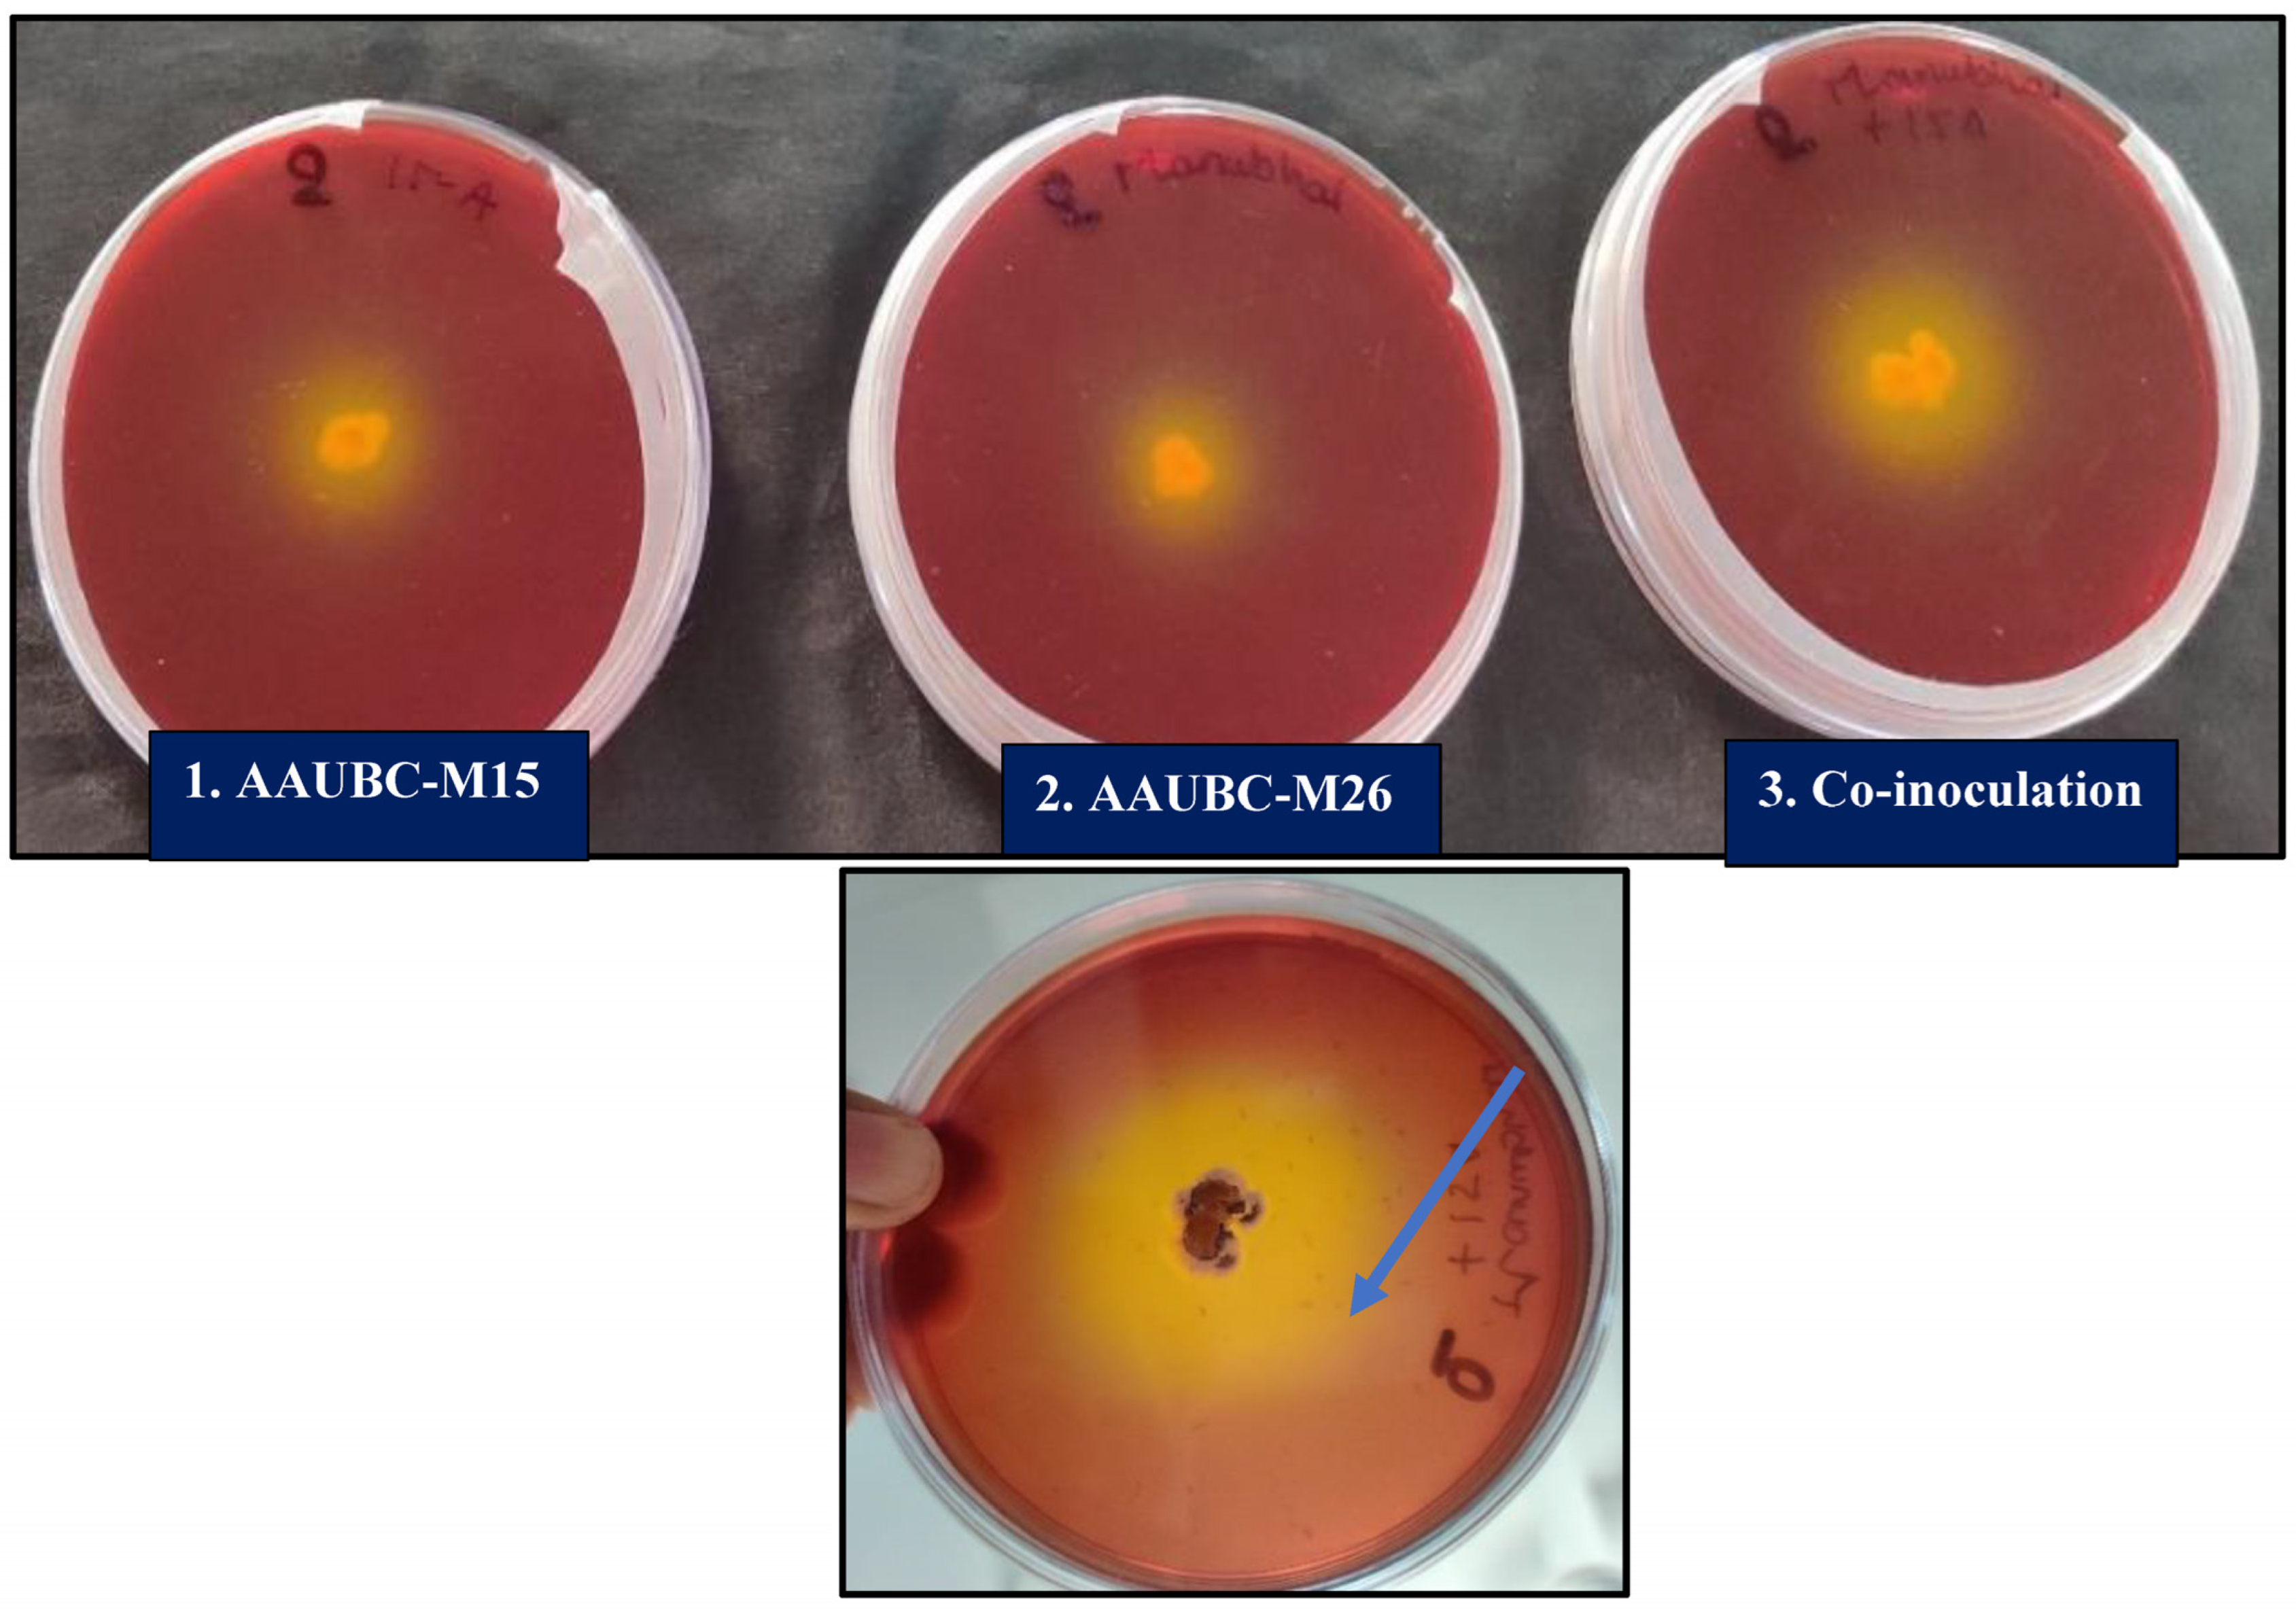
Agronomy 13 01577 g006

Plant Growth-Promoting Potential of Entomopathogenic Fungus Metarhizium pinghaense AAUBC-M26 under Elevated Salt Stress in Tomato
Abstract
1. Introduction
2. Materials and Methods
2.1. Metarhizium Isolates
2.2. Screening of Metarhizium Isolates for Pathogenicity in Pupal Stage of Helicoverpa armigera
2.3. Screening of Metarhizium Isolates for Salt Tolerance
2.4. Analysis of Plant-Growth-Promoting Traits of Metarhizium Isolates at Elevated NaCl Levels
2.5. Indole Acetic Acid (IAA) Production
2.6. Phosphate Solubilization Activity (Agar Plate Assay)
2.7. Phosphate Solubilization Activity (Broth Assay)
2.8. Potash Solubilization Activity
2.9. ACC Deaminase Production
2.10. Chitinase Production
2.11. Quantification of Total Phenolics in the Culture Filtrate of Metarhizium Isolates
2.12. Quantification of Total Flavonoids in the Culture Filtrate of Metarhizium Isolates
2.13. Solid-State Fermentation of Metarhizium Isolates
2.14. Plant-Growth-Promoting and Salt-Stress-Alleviating Potential of Metarhizium Isolates in Tomato during Nursery Stage
2.15. Quantification of Biochemical and Physiological Parameters in Tomato Plants during Nursery Stage
Quantification of Total Proline
2.16. Histology of Tomato Seedlings Root in Nursery Stage
2.17. Plant Growth-Promoting and Salt-Stress-Alleviating Potential of Metarhizium Species in Tomato under Pot Culture Conditions
2.18. Statistical Analysis
3. Results
3.1. Pathogenicity of Metarhizium Isolates in Pupal Stage of H. armigera
3.2. Salinity Stress Tolerance of Metarhizium Isolates
3.3. Plant-Growth-Stimulating Traits at Elevated Salt Stress
3.3.1. IAA Production
3.3.2. Phosphate and Potash Solubilization
3.3.3. ACC-Deaminase and Chitinase Enzyme Activity
3.3.4. Phenolics and Flavonoids Production
3.4. Growth Promotion in Tomato Plant by Metarhizium Species under Salt Stress
4. Discussion
5. Conclusions
Supplementary Materials
Author Contributions
Funding
Data Availability Statement
Acknowledgments
Conflicts of Interest
Nomenclature
| Treatments | |
| T1 | Seedling root dip |
| T2 | Soil application |
| T3 | Foliar spray |
| T4 | Seedling root dip + Soil application |
| T5 | Seedling root dip + Foliar spray |
| T6 | Soil application + Foliar spray |
| T7 | Seedling root dip + Soil application + Foliar spray |
| T8 | Treated control (Salt stress) |
| T9 | Untreated control (No salt stress) |
References
- Elena, G.J.; Beatriz, P.J.; Alejandro, P.; Lecuona, R.E. Metarhizium anisopliae (Metschnikoff) Sorokin promotes growth and has endophytic activity in tomato Plants. Adv. Biol. Res. 2011, 5, 22–27. [Google Scholar]
- Liao, X.; O’Brien, T.R.; Fang, W.; St Leger, R.J. The plant beneficial effects of Metarhizium species correlate with their association with roots. Appl. Microbiol. Biotechnol. 2014, 98, 7089–7096. [Google Scholar] [CrossRef] [PubMed]
- Barelli, L.; Moreira, C.C.; Bidochka, M.J. Initial stages of endophytic colonization by Metarhizium involves rhizoplane colonization. Microbiology 2018, 164, 1531–1540. [Google Scholar] [CrossRef] [PubMed]
- Bidochka, M.J.; Kamp, A.M.; Lavender, T.M.; Dekoning, J.; De Croos, J.A. Habitat association in two genetic groups of the insect-pathogenic fungus Metarhizium anisopliae: Uncovering cryptic species? Appl. Environ. Microbiol. 2001, 67, 1335–1342. [Google Scholar] [CrossRef] [PubMed]
- Agbessenou, A.; Akutse, K.S.; Yusuf, A.A.; Ekesi, S.; Subramanian, S.; Khamis, F.M. Endophytic fungi protect tomato and nightshade plants against Tuta absoluta (Lepidoptera: Gelechiidae) through a hidden friendship and cryptic battle. Sci. Rep. 2020, 10, 22195. [Google Scholar] [CrossRef] [PubMed]
- Hu, S.; Bidochka, M.J. Root colonization by endophytic insect-pathogenic fungi. J. Appl. Microbiol. 2021, 130, 570–581. [Google Scholar] [CrossRef] [PubMed]
- Ahmad, I.; Jiménez-Gasco, M.D.M.; Luthe, D.S.; Barbercheck, M.E. Systemic colonization by Metarhizium robertsii enhances cover crop growth. J. Fungi 2020, 6, 64. [Google Scholar] [CrossRef]
- FAO. Salt-Affected Soils; (Online); FAO: Rome, Italy, 2020. [Google Scholar]
- Srivastava, P.; Wu, Q.S.; Giri, B. Salinity: An overview. In Microorganisms in Saline Environments: Strategies and Functions; Giri, B., Varma, A., Eds.; Springer Nature: Cham, Switzerland, 2019; pp. 3–18. [Google Scholar] [CrossRef]
- Chauhan, P.S.; Lata, C.; Tiwari, S.; Chauhan, A.S.; Mishra, S.K.; Agrawal, L.; Agrawal, L.; Chakrabarty, D.; Nautiyal, C.S. Transcriptional alterations reveal Bacillus amyloliquefaciens-rice cooperation under salt stress. Sci. Rep. 2019, 9, 11912. [Google Scholar] [CrossRef]
- Upadhyay, S.K.; Singh, J.S.; Saxena, A.K.; Singh, D.P. Impact of PGPR inoculation on growth and antioxidant status of wheat under saline conditions. Plant Biol. 2012, 14, 605–611. [Google Scholar] [CrossRef]
- Ansari, F.A.; Ahmad, I.; Pichtel, J. Growth stimulation and alleviation of salinity stress to wheat by the biofilm forming Bacillus pumilus strain FAB10. Appl. Soil Ecol. 2019, 143, 45–54. [Google Scholar] [CrossRef]
- Kang, S.M.; Khan, A.L.; Waqas, M.; You, Y.H.; Kim, J.H.; Kim, J.G.; Hamayun, M.; Lee, I.J. Plant growth-promoting rhizobacteria reduce adverse effects of salinity and osmotic stress by regulating phytohormones and antioxidants in Cucumis sativus. J. Plant Interact. 2014, 9, 673–682. [Google Scholar] [CrossRef]
- Palaniyandi, S.A.; Damodharan, K.; Yang, S.H.; Suh, J.W. Streptomyces sp. strain PGPA39 alleviates salt stress and promotes growth of ‘Micro Tom’ tomato plants. J. Appl. Microbiol. 2014, 117, 766–773. [Google Scholar] [PubMed]
- Schultz, B.; Boyle, C. The endophytic continuum. Mycol. Res. 2005, 109, 661–686. [Google Scholar]
- Rai, M.; Rathod, D.; Agarkar, G.; Dar, M.; Brestic, M.; Pastore, G.M.; Junior, M.R.M. Fungal growth promotor endophytes: A pragmatic approach towards sustainable food and agriculture. Symbiosis 2014, 62, 63–79. [Google Scholar] [CrossRef]
- Strobel, G.; Daisy, B. Bioprospecting for microbial endophytes and their natural products. Microbiol. Mol. Biol. Rev. 2003, 67, 491–502. [Google Scholar] [CrossRef] [PubMed]
- Hyde, K.D.; Soytong, K. The fungal endophyte dilemma. Fungal Divers. 2008, 33, e173. [Google Scholar]
- Khan, S.A.; Hamayun, M.; Yoon, H.; Kim, H.Y.; Suh, S.J.; Hwang, S.K.; Kim, J.M.; Lee, I.J.; Choo, L.Y.; Yoon, U.H.; et al. Plant growth promotion and Penicillium citrinum. BMC Microbiol. 2008, 8, 231. [Google Scholar] [CrossRef]
- Colla, G.; Rouphael, Y.; Di Mattia, E.; El-Nakhel, C.; Cardarelli, M. Co-inoculation of Glomus intraradices and Trichoderma atroviride acts as a biostimulant to promote growth, yield and nutrient uptake of vegetable crops. J. Sci. Food Agri. 2015, 95, 1706–1715. [Google Scholar] [CrossRef]
- Khan, A.L.; Hamayun, M.; Khan, S.A.; Kang, S.M.; Shinwari, Z.K.; Kamran, M.; Rehman, S.; Kim, J.G.; Lee, I.J. Pure culture of Metarhizium anisopliae LHL07 reprograms soybean to higher growth and mitigates salt stress. World J. Microbiol. Biotechnol. 2011, 28, 1483–1494. [Google Scholar] [CrossRef]
- Luz, C.; Rocha, L.F.N.; Montalva, C.; Souza, D.A.; Botelho, B.R.Z.; Lopes, R.B.; Faria, M.; Junior, I.D. Metarhizium humberi sp. nov. (Hypocreales: Clavicipitaceae), a new member of the PARB clade in the Metarhizium anisopliae complex from Latin America. J. Invertebr. Pathol. 2019, 166, 107216. [Google Scholar] [CrossRef]
- Goettel, M.S.; Inglis, G.D. Fungi: Hyphomycetes. In Manual of Techniques in Insect Pathology; Academic Press: Lacey, WA, USA, 1997; pp. 213–249. [Google Scholar] [CrossRef]
- Porcel, R.; Aroca, R.; Ruiz-Lozano, J.M. Salinity stress alleviation using arbuscular mycorrhizal fungi. A review. Agron. Sustain. Develop. 2012, 32, 181–200. [Google Scholar] [CrossRef]
- Patten, C.L.; Glick, B.R. Bacterial biosynthesis of indole-3-acetic acid. Can. J. Microbiol. 1996, 42, 207–220. [Google Scholar] [CrossRef] [PubMed]
- Gordon, S.A.; Weber, R.P. Colorimetric estimation of indole acetic acid. Plant Physiol. 1951, 26, 192. [Google Scholar] [CrossRef]
- El-Azouni, I.M. Effect of phosphate solubilizing fungi on growth and nutrient uptake of soybean (Glycine max L.) plants. J. Appl. Sci. Res. 2008, 4, 592–598. [Google Scholar]
- APHA. Standard Methods for the Examination of Water and Waste Water, 21st ed.; American Public Health Association: Washington, DC, USA, 2005. [Google Scholar]
- Hu, X.; Chen, J.; Guo, J. Two phosphate and potassium solubilizing bacteria isolated from Tianmu Mountain, Zhejiang, China. World J. Microbiol. Biotech. 2006, 22, 983–990. [Google Scholar] [CrossRef]
- Duan, J.; Müller, K.M.; Charles, T.C.; Vesely, S.; Glick, B.R. 1-aminocyclopropane-1-carboxylate (ACC) deaminase genes in Rhizobia from southern Saskatchewan. Microb. Ecol. 2009, 57, 423–436. [Google Scholar] [CrossRef]
- Agrawal, T.; Kotasthane, A.S. Chitinolytic assay of indigenous Trichoderma isolates collected from different geographical locations of Chhattisgarh in Central India. SpringerPlus 2012, 1, 73. [Google Scholar] [CrossRef]
- Qawasmeh, A.; Obied, H.K.; Raman, A.; Wheatley, W. Influence of fungal endophyte infection on phenolic content and antioxidant activity in grasses: Interaction between Lolium perenne and different strains of Neotyphodium lolii. J. Agric. Food Chem. 2012, 60, 3381–3388. [Google Scholar] [CrossRef]
- Srinivasan, K.; Jagadish, L.K.; Shenbhagaraman, R.; Muthumary, J. Antioxidant activity of endophytic fungus Phyllosticta sp. isolated from Guazuma tomentosa. J. Phytol. Phytochem. 2010, 2, 37–41. [Google Scholar]
- Abdul-Baki, A.A.; Anderson, J.D. Vigor determination in soybean seed by multiple criteria. Crop Sci. 1973, 13, 630. [Google Scholar] [CrossRef]
- Shaw, J.J.; Spakowicz, D.J.; Dalal, R.S.; Davis, J.H.; Lehr, N.A.; Dunican, B.F.; Orellana, E.A.; Narvaez-Trujillo, A.; Strobel, S.A. Biosynthesis and genomic analysis of medium-chain hydrocarbon production by the endophytic fungal isolate Nigrograna mackinnonii E5202H. Appl. Microbiol. Biotech. 2018, 99, 3715–3728. [Google Scholar] [CrossRef] [PubMed]
- O’Brien, T.; Feder, N.; McCully, M.E. Polychromatic staining of plant cell walls by toluidine blue O. Protoplasma 1964, 59, 368–373. [Google Scholar] [CrossRef]
- Jackson, M.L. Soil Chemical Analysis; Prentic Hall Idia Pvt. Ltd.: New Delhi, India, 1973. [Google Scholar]
- Tahir, M.; Wakil, W.; Ali, A.; Sahi, S.T. Pathogenicity of Beauveria bassiana and Metarhizium anisopliae isolates against larvae of the polyphagous pest Helicoverpa armigera. Entomol. Gen. 2018, 38, 225–242. [Google Scholar] [CrossRef]
- Ramanujam, B.; Hosamani, A.; Poornesha, B.; Sowmya, E. Biological control of white grubs, Holotrichia serrata (Fabricius) in sugarcane by two species of entomopathogenic fungi, Metarhizium anisopliae and Beauveria bassiana. Int. J. Trop. Insect. Sci. 2021, 41, 671–680. [Google Scholar] [CrossRef]
- Gupta, S.; Schillaci, M.; Walker, R.; Smith, P.M.; Watt, M.; Roessner, U. Alleviation of salinity stress in plants by endophytic plant-fungal symbiosis: Current knowledge, perspectives and future directions. Plant Soil 2021, 461, 219–244. [Google Scholar] [CrossRef]
- Klinsukon, C.; Lumyong, S.; Kuyper, T.W.; Boonlue, S. Colonization by arbuscular mycorrhizal fungi improves salinity tolerance of eucalyptus (Eucalyptus camaldulensis) seedlings. Sci. Rep. 2021, 11, 1–10. [Google Scholar] [CrossRef]
- Jan, F.G.; Hamayun, M.; Hussain, A.; Iqbal, A.; Jan, G.; Khan, S.A.; Khan, H.; Lee, I.J. A promising growth promoting Meyerozyma caribbica from Solanum xanthocarpum alleviated stress in maize plants. Biosci. Rep. 2019, 39, BSR20190290. [Google Scholar] [CrossRef]
- Badawy, A.A.; Alotaibi, M.O.; Abdelaziz, A.M.; Osman, M.S.; Khalil, A.M.; Saleh, A.M.; Mohammed, E.F.; Hashem, A.H. Enhancement of seawater stress tolerance in barley by the endophytic fungus Aspergillus ochraceus. Metabolites 2021, 11, 428. [Google Scholar] [CrossRef]
- Fu, S.F.; Sun, P.F.; Lu, H.Y.; Wei, J.Y.; Xiao, H.S.; Fang, W.T.; Cheng, B.Y.; Chou, J.Y. Plant growth-promoting traits of yeasts isolated from the phyllosphere and rhizosphere of Drosera spatulata Lab. Fungal Biol. 2016, 120, 433–448. [Google Scholar] [CrossRef]
- Rana, K.L.; Kour, D.; Sheikh, I.; Yadav, N. Advances in Endophytic Fungal Research; Springer International Publishing: New York, NY, USA, 2019; Available online: https://www.springer.com/gp/book/9783030035884 (accessed on 29 March 2023).
- Liao, X.; Lovett, B.; Fang, W.; St Leger, R.J. Metarhizium robertsii produces indole-3-acetic acid, which promotes root growth in Arabidopsis and enhances virulence to insects. Microbiology 2017, 163, 980–991. [Google Scholar] [CrossRef]
- Siqueira, A.C.O.; Mascarin, G.M.; Gonçalves, C.R.; Marcon, J.; Quecine, M.C.; Figueira, A.; Delalibera, Í., Jr. Multi-trait biochemical features of Metarhizium species and their activities that stimulate the growth of tomato plants. Front. Sustain. Food Syst. 2020, 4, 137. [Google Scholar] [CrossRef]
- Gouda, S.; Kerry, R.G.; Das, G.; Paramithiotis, S.; Shin, H.S.; Patra, J.K. Revitalization of plant growth promoting rhizobacteria for sustainable development in agriculture. Microbiol. Res. 2018, 206, 131–140. [Google Scholar] [CrossRef] [PubMed]
- Gan, Z.; Yang, J.; Tao, N.; Liang, L.; Mi, Q.; Li, J.; Zhang, K. Cloning of the gene Lecanicillium psalliotae chitinase Lpchi1 and identification of its potential role in the biocontrol of root-knot nematode Meloidogyne incognita. Appl. Microbiol. Biotechnol. 2007, 76, 1309–1317. [Google Scholar] [CrossRef] [PubMed]
- Hamayun, M.; Hussain, A.; Afzal Khan, S.; Iqbal, A.; Lee, I.J. Aspergillus flavus promoted the growth of soybean and sunflower seedlings at elevated temperature. BioMed Res. Int. 2019, 2019, 1295457. [Google Scholar] [CrossRef]
- Dutta, P.; Kaushik, H.; Bhawmick, P.; Puzari, K.C.; Hazarika, G.N. Metarhizium anisopliae as endophyte has the ability of plant growth enhancement. Int. J. Curr. Res. 2015, 7, 14300–14304. [Google Scholar]
- Lei, P.; Xu, Z.; Liang, J.; Luo, X.; Zhang, Y.; Feng, X. Poly (γ-glutamic acid) enhanced tolerance to salt stress by promoting proline accumulation in Brassica napus L. Plant Growth Regul. 2016, 78, 233. [Google Scholar] [CrossRef]
- Khan, M.N.; Siddiqui, M.H.; Mohammad, F.; Naeem, M.; Khan, M.M.A. Calcium chloride and gibberellic acid protect linseed (Linum usitatissimum L.) from NaCl stress by inducing antioxidative defence system and osmoprotectant accumulation. Acta Physiol. Planta. 2010, 32, 121. [Google Scholar] [CrossRef]
- Dave, A.; Ingle, S. Streptomyces sp. S-9 promotes plant growth and confers resistance in pigeon pea (Cajanus cajan) against Fusarium wilt. 3 Biotech 2021, 11, 459. [Google Scholar] [CrossRef]

| Metarhizium Species and Isolate Code | Source/Isolation Method | Source Location with GPS Co-Ordinates | Date of Sampling |
|---|---|---|---|
| Metarhizium robertsii- AAUBC-M7 | Soil/Insect bait with Corcyra cephalonica | Village: Mendarda, Dist: Junagadh, Gujarat (India) (21.3209° N, 70.4412° E) | 12 July 2020 |
| Metarhizium anisopliae- AAUBC-M15 | Forest soil/Insect bait with Corcyra cephalonica | Village: Hiranvel, Dist. GirSomnath, Gujarat (India) (21.1398° N, 70.5100° E) | 15 December 2020 |
| Metarhizium anisopliae- AAUBC-M21 | Forest soil/Insect bait with Corcyra cephalonica | Village: Hiranvel, Dist. GirSomnath, Gujarat (India) (21.1398° N, 70.5100° E) | 31 December 2020 |
| Metarhizium anisopliae- AAUBC-M22 | Maize soil/Selective medium (PDAY) | Village: Runaj, Dist. Anand, Gujarat (India) (22.5025° N, 72.7009° E) | 27 December 2019 |
| Metarhizium pinghaense- AAUBC-M26 | Maize soil/Insect bait with Corcyra cephalonica | Village: Jahangirpura, Dist. Anand, Gujarat (India) (22.5288° N, 72.9828° E) | 20 December 2019 |
| Metarhizium robertsii- AAUBC-M27 | Cucumber soil/Selective medium (PDAY) | Village: Bochasan, Dist. Anand, Gujarat (India) (22.4097° N, 72.8416° E) | 31 January 2019 |
| Treatments | Germination Percentage (%) | Plant Height (cm) | Vigor Index | Seedling Fresh Weight (g) | Seedling Dry Weight (g) | |
|---|---|---|---|---|---|---|
| T1 | Untreated control | 94.61 ab | 11.42 d | 1052.62 bc | 1.41 b | 0.55 c |
| T2 | Treated control (50 mM NaCl) | 79.75 d | 8.25 e | 666.51 d | 1.10 c | 0.49 d |
| T3 | M. anisopliae (AAUBC-M15) + 50 mM NaCl | 87.89 bc | 16.07 c | 1410.49 c | 1.85 b | 0.66 bcd |
| T4 | M. anisopliae AAUBC-M15 | 95.16 ab | 19.40 b | 1828.57 ab | 2.01 a | 0.76 ab |
| T5 | M. pinghaense (AAUBC-M26) + 50 mM NaCl | 89.60 bc | 16.83 c | 1494.97 c | 1.92 b | 0.71 abc |
| T6 | M. pinghaense (AAUBC-M26) | 96.56 a | 20.73 a | 1967.55 a | 2.11 a | 0.88 a |
Disclaimer/Publisher’s Note: The statements, opinions and data contained in all publications are solely those of the individual author(s) and contributor(s) and not of MDPI and/or the editor(s). MDPI and/or the editor(s) disclaim responsibility for any injury to people or property resulting from any ideas, methods, instructions or products referred to in the content. |
© 2023 by the authors. Licensee MDPI, Basel, Switzerland. This article is an open access article distributed under the terms and conditions of the Creative Commons Attribution (CC BY) license (https://creativecommons.org/licenses/by/4.0/).
Share and Cite
Chaudhary, P.J.; B. L., R.; Patel, H.K.; Mehta, P.V.; Patel, N.B.; Sonth, B.; Dave, A.; Bagul, S.Y.; M., D.; Jain, D.; et al. Plant Growth-Promoting Potential of Entomopathogenic Fungus Metarhizium pinghaense AAUBC-M26 under Elevated Salt Stress in Tomato. Agronomy 2023, 13, 1577. https://doi.org/10.3390/agronomy13061577
Chaudhary PJ, B. L. R, Patel HK, Mehta PV, Patel NB, Sonth B, Dave A, Bagul SY, M. D, Jain D, et al. Plant Growth-Promoting Potential of Entomopathogenic Fungus Metarhizium pinghaense AAUBC-M26 under Elevated Salt Stress in Tomato. Agronomy. 2023; 13(6):1577. https://doi.org/10.3390/agronomy13061577
Chicago/Turabian StyleChaudhary, Priyanka J., Raghunandan B. L., Hiren K. Patel, Punit V. Mehta, Nainesh B. Patel, Bandeppa Sonth, Anand Dave, Samadhan Y. Bagul, Divya M., Devendra Jain, and et al. 2023. "Plant Growth-Promoting Potential of Entomopathogenic Fungus Metarhizium pinghaense AAUBC-M26 under Elevated Salt Stress in Tomato" Agronomy 13, no. 6: 1577. https://doi.org/10.3390/agronomy13061577
APA StyleChaudhary, P. J., B. L., R., Patel, H. K., Mehta, P. V., Patel, N. B., Sonth, B., Dave, A., Bagul, S. Y., M., D., Jain, D., Alsahli, A. A., & Kaushik, P. (2023). Plant Growth-Promoting Potential of Entomopathogenic Fungus Metarhizium pinghaense AAUBC-M26 under Elevated Salt Stress in Tomato. Agronomy, 13(6), 1577. https://doi.org/10.3390/agronomy13061577

